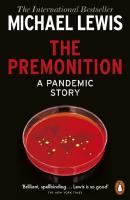
The Premonition

-

Flash Boys - Cracking the money code
Inbunden bok. Penguin. 2014. 274 sidor.
Mycket gott skick. Skyddsomslag i mycket gott skick. Språk: Engelska.
Michael Lewis is back with Flash Boys, the headline-grabbing, game-changing international bestseller exposing the underworld of global finance
If you thought Wall Street was about alpha males standing in trading pits hollering at eac läs mer … läs merInrikes enhetsfrakt Sverige: 62 SEK- ISBN
- 9780241003633
- Titel
- Flash Boys
- Författare
- Michael Lewis
- Förlag
- Penguin
- Utgivningsår
- 2014
- Bandtyp
- Inbunden
- Mått
- 160 x 240 mm Ryggbredd 27 mm
- Vikt
- 520 g
- Språk
- English
Penguin 9780241003633 -

Who Is Government?: The Untold Story of Publi...
Inbunden bok.
Nyskick. Skyddsomslag i nyskick. Penguin Random House USA. 2025. 272 sidor. Oläst. Förlagsny.
Inrikes enhetsfrakt Sverige: 62 SEK- ISBN
- 9798217047802
- Titel
- Who Is Government? - The Untold Story of Public Service
- Författare
- Lewis, Michael
- Förlag
- Penguin Random House USA
- Utgivningsår
- 2025
- Omfång
- 272 sidor
- Bandtyp
- Inbunden
- Språk
- English
9798217047802 -

Flash Boys : Uppror på Wall Street
Pocketbok.
Nyskick. Modernista Group. 1 uppl. 2017. 281 sidor. Oläst. Förlagsny.
Inrikes enhetsfrakt Sverige: 62 SEK- ISBN
- 9789177016229
- Titel
- Flash Boys : Uppror på Wall Street
- Författare
- Lewis, Michael
- Förlag
- Modernista
- Utgivningsår
- 2017
- Omfång
- 281 sidor
- Bandtyp
- Mått
- 111 x 179 mm Ryggbredd 18 mm
- Vikt
- 160 g
- Språk
- Svenska
- Baksidestext
- Av författaren till THE BIG SHORT
#1 på New York Times Bestsellerlista
»Få har bättre koll på Wall Street än författaren Michael Lewis. Ingen annan amerikan jag känner till skriver åtminstone lika underhållande om pengar och makt.« | Jan Eklund, Dagens Nyheter
»Ingen skriver bättre om siffror och pengar än Michael Lewis.« | Jan Gradvall, DI
»Skrev jag att boken var spännande? Trots att den handlar om teknik och aktieaffärer lyckas han skapa en verklighetens thriller.« | Ernst Klein, Norrköpings Tidningar
I Flash Boys skildrar ekonomijournalisten och författaren Michael Lewis hur en liten grupp upprorsmakare på Wall Street börjar inse att den amerikanska aktiemarknaden har riggats för att gynna folk på insidan. De slår sig samman några av dem lämnar jobb med astronomiska löner bakom sig för att utforska, avslöja och reformera det bedrägliga sätt som Wall Street genererar pengar på genom högfrekvenshandel.
Flash Boys är oumbärlig läsning för alla som är intresserade av börshandel och Wall Street. Samtidigt är det en så spännande historia, så skickligt berättad, att vem som helst kommer att få svårt att lägga boken ifrån sig.
MICHAEL LEWIS är den storsäljande författaren till The Big Short, Liar s Poker, Moneyball och The Blind Side. Han bor i Berkeley i Kalifornien.
»Det här är facklitteratur, men till sin uppbyggnad liknar boken en spänningsroman.« | Kari Kapla, Dagens bok
»När vår tids historia ska berättas kommer det inte att finnas några mer oumbärliga dokument än Michael Lewis böcker. Flash Boys fullbordar en trilogi som kartlägger den högst mänskliga historien om de senaste 30 årens globala korrumption av finansmarknaderna, kanske vår epoks viktigaste men minst förstådda brott.« | The Guardian
»En mycket underhållande bok, som belyser hur mycket världen har förändrats på mindre än ett decennium.« | Los Angeles Times
»Michael Lewis är ett geni och hans bok kommer att leda till en välbehövlig granskning av högfrekvenshandeln.« | New York Magazine
»Kommer garanterat att få blodet att koka hos många.« | New York Times
»Fullkomligt uppslukande.« | New York Review of Books
»Spännande som en thriller.« | London Review of Books
9789177016229 -
 Inrikes enhetsfrakt Sverige: 62 SEK
Inrikes enhetsfrakt Sverige: 62 SEK- ISBN
- 9781802063516
- Titel
- Going Infinite
- Författare
- Lewis, Michael
- Förlag
- Penguin
- Utgivningsår
- 2024
- Omfång
- 320 sidor
- Bandtyp
- Mått
- 128 x 198 mm Ryggbredd 16 mm
- Vikt
- 220 g
- Språk
- English
- Baksidestext
- Sam Bankman-Fried wasn't just rich. Before he turned thirty he'd become the world's youngest billionaire, making a record fortune in the crypto frenzy. CEOs, celebrities and world leaders vied for his time. At one point he considered paying off the entire national debt of the Bahamas so he could take his business there. Then it all fell apart. Who was this Gatsby of the crypto world, a rumpled guy in cargo shorts, whose eyes twitched across TV interviews as he played video games on the side, who even his million-dollar investors still found a mystery? What gave him such an extraordinary ability to make money - and how did his empire collapse so spectacularly? Michael Lewis was there when it happened, having got to know Bankman-Fried during his epic rise. In Going Infinite he tells us a story like no other, taking us through the mind-bending trajectory of a character who never liked the rules and was allowed to live by his own. Both psychological portrait of a preternaturally gifted 'thinking machine', and wild financial roller-coaster ride, this is a twenty-first-century epic of high-frequency trading and even higher stakes, of crypto mania and insane amounts of money, of hubris and downfall. No one could tell it better.
9781802063516 -

The big short : den sanna historien bakom årh...
Pocketbok. Modernista. 2020. 287 sidor.
Mycket gott skick.
Inrikes enhetsfrakt Sverige: 62 SEK- ISBN
- 9789178932566
- Titel
- The big short : den sanna historien bakom århundradets finanskris
- Författare
- Lewis, Michael
- Förlag
- Modernista
- Utgivningsår
- 2020
- Omfång
- 287 sidor
- Bandtyp
- Mått
- 110 x 178 mm Ryggbredd 20 mm
- Vikt
- 152 g
- Språk
- Svenska
- Baksidestext
- Bästsäljaren bakom den Oscarsbelönade filmen!»Ingen skriver bättre om siffror och pengar än Michael Lewis.« | JAN GRADVALL, DI »Jag läser Lewis av samma skäl som jag tittar på Tiger Woods. Jag kommer aldrig att spela på samma nivå, men det är bra att bli påmind då och då om hur genialitet ser ut.« | MALCOLM GLADWELL, NY TIMES BOOK REVIEW När finanskraschen på den amerikanska aktiemarknaden blev allmänt känd 2008 hade den egentligen redan pågått ett bra tag i det dolda. Den verkliga historien började nämligen på bisarra marknader, dit solljuset inte nådde och där tillsynsmyndigheterna inte ville befinna sig. Marknader där skygga genier och särlingar överlistade hela finansmarknaden och tjänade enorma summor på amerikaner som inte kunde betala sina skulder.
De insiktsfulla personer som förstod vad som hände, eller kanske hände, var paralyserade av hopp och rädsla; hur som helst sade de ingenting. Michael Lewis skriver en uppslukande, karaktärsdriven berättelse, sprängfylld av indignation och svart humor. Utifrån en handfull osannolika - verkligt osannolika - hjältar, skapar Lewis en berättelse som än en gång bevisar att han är en av de skarpaste och mest underhållande skildrarna av vår tid. MICHAEL LEWIS är den storsäljande författaren till The Big Short, The Blind Side, Liars Poker och Flash Boys. 2015 kom filmversionen av The Big Short - med Brad Pitt och Christian Bale i två av rollerna - som gjort stor succé på bio och vunnit en rad priser, bland annat en Oscar i kategorin Bästa manus efter förlaga. Michael Lewis bor i Berkeley i Kalifornien med hustru och tre barn.
Modernista 9789178932566 -

Origins of intelligence - infancy and early c...
Inbunden bok. Plenum. 1976. 413 sidor.
Mycket gott skick. Skyddsomslag i gott skick. Fint exemplar. Skyddsomslaget slitet med revor och riss både fram och bak. Pärm och inlaga i mycket gott skick. På engelska.
Inrikes enhetsfrakt Sverige: 62 SEK- ISBN
- 9780306308673
- Titel
- Origins of intelligence - infancy and early childhood
- Förlag
- Plenum
- Utgivningsår
- 1976
- Språk
- English
Plenum 9780306308673 -
 Inrikes enhetsfrakt Sverige: 62 SEK
Inrikes enhetsfrakt Sverige: 62 SEK- ISBN
- 9780393351590
- Titel
- Flash Boys
- Författare
- Michael Lewis
- Förlag
- Wiley
- Utgivningsår
- 2015
- Bandtyp
- Mått
- 139 x 209 mm Ryggbredd 19 mm
- Vikt
- 250 g
- Språk
- English
Wiley 9780393351590 -

The Money Culture
Pocketbok.
ISBN 9780140176032
Gott skick. Penguin Books. New York, 1992. Pocket. De första sex bladen lätt veckade. Två hundöron. xv + 282 s.
Inrikes enhetsfrakt Sverige: 62 SEK9780140176032 -
 Inrikes enhetsfrakt Sverige: 62 SEK
Inrikes enhetsfrakt Sverige: 62 SEK- ISBN
- 9789178932566
- Titel
- The big short : den sanna historien bakom århundradets finanskris
- Författare
- Lewis, Michael
- Förlag
- Modernista
- Utgivningsår
- 2020
- Omfång
- 287 sidor
- Bandtyp
- Mått
- 110 x 178 mm Ryggbredd 20 mm
- Vikt
- 152 g
- Språk
- Svenska
- Baksidestext
- Bästsäljaren bakom den Oscarsbelönade filmen!»Ingen skriver bättre om siffror och pengar än Michael Lewis.« | JAN GRADVALL, DI »Jag läser Lewis av samma skäl som jag tittar på Tiger Woods. Jag kommer aldrig att spela på samma nivå, men det är bra att bli påmind då och då om hur genialitet ser ut.« | MALCOLM GLADWELL, NY TIMES BOOK REVIEW När finanskraschen på den amerikanska aktiemarknaden blev allmänt känd 2008 hade den egentligen redan pågått ett bra tag i det dolda. Den verkliga historien började nämligen på bisarra marknader, dit solljuset inte nådde och där tillsynsmyndigheterna inte ville befinna sig. Marknader där skygga genier och särlingar överlistade hela finansmarknaden och tjänade enorma summor på amerikaner som inte kunde betala sina skulder.
De insiktsfulla personer som förstod vad som hände, eller kanske hände, var paralyserade av hopp och rädsla; hur som helst sade de ingenting. Michael Lewis skriver en uppslukande, karaktärsdriven berättelse, sprängfylld av indignation och svart humor. Utifrån en handfull osannolika - verkligt osannolika - hjältar, skapar Lewis en berättelse som än en gång bevisar att han är en av de skarpaste och mest underhållande skildrarna av vår tid. MICHAEL LEWIS är den storsäljande författaren till The Big Short, The Blind Side, Liars Poker och Flash Boys. 2015 kom filmversionen av The Big Short - med Brad Pitt och Christian Bale i två av rollerna - som gjort stor succé på bio och vunnit en rad priser, bland annat en Oscar i kategorin Bästa manus efter förlaga. Michael Lewis bor i Berkeley i Kalifornien med hustru och tre barn.
Modernista 9789178932566 -

Flash Boys: Uppror på Wall Street
Inbunden bok. Modernista. 2016. 281 sidor.
Nyskick. Skyddsomslag i nyskick. I Flash Boys skildrar ekonomijournalisten och författaren Michael Lewis hur en liten grupp upprorsmakare på Wall Street börjar inse att den amerikanska aktiemarknaden har riggats för att gynna folk på insidan. De slår sig samman några av dem lämnar jobb läs mer … läs mer
Inrikes enhetsfrakt Sverige: 62 SEK- ISBN
- 9789176458518
- Titel
- Flash Boys : Uppror på Wall Street
- Författare
- Lewis, Michael
- Förlag
- Modernista
- Utgivningsår
- 2016
- Omfång
- 281 sidor
- Bandtyp
- Inbunden
- Mått
- 146 x 217 mm Ryggbredd 27 mm
- Vikt
- 520 g
- Språk
- Svenska
- Baksidestext
- Av författaren till THE BIG SHORT
#1 på New York Times Bestsellerlista
»Få har bättre koll på Wall Street än författaren Michael Lewis. Ingen annan amerikan jag känner till skriver åtminstone lika underhållande om pengar och makt.« | Jan Eklund, Dagens Nyheter
»Ingen skriver bättre om siffror och pengar än Michael Lewis.« | Jan Gradvall, DI
»Skrev jag att boken var spännande? Trots att den handlar om teknik och aktieaffärer lyckas han skapa en verklighetens thriller.« | Ernst Klein, Norrköpings Tidningar
I Flash Boys skildrar ekonomijournalisten och författaren Michael Lewis hur en liten grupp upprorsmakare på Wall Street börjar inse att den amerikanska aktiemarknaden har riggats för att gynna folk på insidan. De slår sig samman några av dem lämnar jobb med astronomiska löner bakom sig för att utforska, avslöja och reformera det bedrägliga sätt som Wall Street genererar pengar på genom högfrekvenshandel.
Flash Boys är oumbärlig läsning för alla som är intresserade av börshandel och Wall Street. Samtidigt är det en så spännande historia, så skickligt berättad, att vem som helst kommer att få svårt att lägga boken ifrån sig.
MICHAEL LEWIS är den storsäljande författaren till The Big Short, Liar s Poker, Moneyball och The Blind Side. Han bor i Berkeley i Kalifornien.
»Det här är facklitteratur, men till sin uppbyggnad liknar boken en spänningsroman.« | Kari Kapla, Dagens bok
»När vår tids historia ska berättas kommer det inte att finnas några mer oumbärliga dokument än Michael Lewis böcker. Flash Boys fullbordar en trilogi som kartlägger den högst mänskliga historien om de senaste 30 årens globala korrumption av finansmarknaderna, kanske vår epoks viktigaste men minst förstådda brott.« | The Guardian
»En mycket underhållande bok, som belyser hur mycket världen har förändrats på mindre än ett decennium.« | Los Angeles Times
»Michael Lewis är ett geni och hans bok kommer att leda till en välbehövlig granskning av högfrekvenshandeln.« | New York Magazine
»Kommer garanterat att få blodet att koka hos många.« | New York Times
»Fullkomligt uppslukande.« | New York Review of Books
»Spännande som en thriller.« | London Review of Books
Modernista 9789176458518 -
 Inrikes enhetsfrakt Sverige: 62 SEK
Inrikes enhetsfrakt Sverige: 62 SEK- ISBN
- 9780340839966
- Titel
- Liar's poker
- Författare
- Lewis, Michael M.
- Förlag
- London : Hodder & Stoughton
- Språk
- English
London : Hodder & Stoughton 9780340839966 -
 Inrikes enhetsfrakt Sverige: 62 SEK
Inrikes enhetsfrakt Sverige: 62 SEK- ISBN
- 9780393353150
- Titel
- The Big Short (Film Tie-In)
- Författare
- Michael Lewis
- Förlag
- Wiley
- Utgivningsår
- 2016
- Bandtyp
- Mått
- 139 x 210 mm Ryggbredd 22 mm
- Vikt
- 290 g
- Språk
- English
Wiley 9780393353150 -

Värstingar på Wall Street : rapport från en d...
Inbunden bok. Reverb. 1 uppl. 2011. 276 sidor.
Nyskick. Skyddsomslag i nyskick. Den verkliga historien om kraschen började på bisarra matarmarknader där solen inte skiner och SEC inte vågar, eller bryr sig, om att beträda: obligations- och fastighetsderivatmarknaderna där nördar uppfinner ogenomträngliga värdepapper för att tjäna pen läs mer … läs mer
Inrikes enhetsfrakt Sverige: 62 SEK- ISBN
- 9789185697335
- Titel
- Värstingar på Wall Street : rapport från en domedagsmaskin
- Författare
- Michael Lewis
- Förlag
- Reverb
- Utgivningsår
- 2011
- Omfång
- 276 sidor
- Bandtyp
- Inbunden
- Mått
- 145 x 215 mm Ryggbredd 23 mm
- Vikt
- 385 g
- Språk
- Svenska
- Baksidestext
- Samtidigt som Wall Street var sysselsatta med att skapa historiens största kreditbubbla anade ett antal outsiderinvesterare att den snart skulle explodera De satsade allt mot banksystemet och tjänade en förmögenhet.
Den hyllade ekonomiskribenten Michael Lewis berättar i Värstingar på Wall Street Rapport från en domedagsmaskin den skandalösa historien om hur det gick till när en blandning av skygga genier och missanpassade särlingar överlistade hela finansmarknaden.
När finanskraschen på den amerikanska aktiemarknaden först blev allmänt känd 2008 var den egentligen redan gårdagens nyheter. Det riktiga sammanbrottet, den ljudlösa kraschen, hade redan ägt rum på bisarra marknader nedsudlade med obegripliga värdepapper skapade för att profitera på amerikaner som inte kunde betala sina skulder. De personer som borde ha haft insikten att förutspå det oundvikliga blev paralyserade av blint hopp eller fruktan. De som kunde ha förhindrat det valde att tiga.
Finanskrisen är egentligen en omöjlig berättelse: tekniskt komplicerad och med huvudpersoner som inte ens själva begrep vad de höll på med, men Michael Lewis lyckas med det omöjliga han förvandlar finanskrisen till en engagerad sidvändare med utgångspunkt från de färgstarka aktörer som lyckades komma ut på andra sidan som vinnare.
Värstingar på Wall Street är en briljant, karaktärsdriven och svart humoristisk berättelse om hur vår ekonomi kördes i botten.
Reverb 1 9789185697335 -

Flash Boys : Uppror på Wall Street
Inbunden bok. Modernista. 2016. 281 sidor.
Gott skick. Skyddsomslag i gott skick. Något snedläst, annars fint. Gallrat ex.
Inrikes enhetsfrakt Sverige: 62 SEK- ISBN
- 9789176458518
- Titel
- Flash Boys : Uppror på Wall Street
- Författare
- Lewis, Michael
- Förlag
- Modernista
- Utgivningsår
- 2016
- Omfång
- 281 sidor
- Bandtyp
- Inbunden
- Mått
- 146 x 217 mm Ryggbredd 27 mm
- Vikt
- 520 g
- Språk
- Svenska
- Baksidestext
- Av författaren till THE BIG SHORT
#1 på New York Times Bestsellerlista
»Få har bättre koll på Wall Street än författaren Michael Lewis. Ingen annan amerikan jag känner till skriver åtminstone lika underhållande om pengar och makt.« | Jan Eklund, Dagens Nyheter
»Ingen skriver bättre om siffror och pengar än Michael Lewis.« | Jan Gradvall, DI
»Skrev jag att boken var spännande? Trots att den handlar om teknik och aktieaffärer lyckas han skapa en verklighetens thriller.« | Ernst Klein, Norrköpings Tidningar
I Flash Boys skildrar ekonomijournalisten och författaren Michael Lewis hur en liten grupp upprorsmakare på Wall Street börjar inse att den amerikanska aktiemarknaden har riggats för att gynna folk på insidan. De slår sig samman några av dem lämnar jobb med astronomiska löner bakom sig för att utforska, avslöja och reformera det bedrägliga sätt som Wall Street genererar pengar på genom högfrekvenshandel.
Flash Boys är oumbärlig läsning för alla som är intresserade av börshandel och Wall Street. Samtidigt är det en så spännande historia, så skickligt berättad, att vem som helst kommer att få svårt att lägga boken ifrån sig.
MICHAEL LEWIS är den storsäljande författaren till The Big Short, Liar s Poker, Moneyball och The Blind Side. Han bor i Berkeley i Kalifornien.
»Det här är facklitteratur, men till sin uppbyggnad liknar boken en spänningsroman.« | Kari Kapla, Dagens bok
»När vår tids historia ska berättas kommer det inte att finnas några mer oumbärliga dokument än Michael Lewis böcker. Flash Boys fullbordar en trilogi som kartlägger den högst mänskliga historien om de senaste 30 årens globala korrumption av finansmarknaderna, kanske vår epoks viktigaste men minst förstådda brott.« | The Guardian
»En mycket underhållande bok, som belyser hur mycket världen har förändrats på mindre än ett decennium.« | Los Angeles Times
»Michael Lewis är ett geni och hans bok kommer att leda till en välbehövlig granskning av högfrekvenshandeln.« | New York Magazine
»Kommer garanterat att få blodet att koka hos många.« | New York Times
»Fullkomligt uppslukande.« | New York Review of Books
»Spännande som en thriller.« | London Review of Books
Modernista 9789176458518 -
 Inrikes enhetsfrakt Sverige: 62 SEK
Inrikes enhetsfrakt Sverige: 62 SEK- ISBN
- 9780141996578
- Titel
- The Premonition
- Författare
- Lewis, Michael
- Förlag
- Penguin
- Utgivningsår
- 2022
- Omfång
- 336 sidor
- Bandtyp
- Mått
- 128 x 198 mm Ryggbredd 18 mm
- Vikt
- 238 g
- Språk
- English
- Baksidestext
- In January 2020, as people started dying from a new virus in Wuhan, China, few really understood the magnitude of what was happening. Except, that is, a small group of scientific misfits who in their different ways had been obsessed all their lives with how viruses spread and replicated - and with why the governments and the institutions that were supposed to look after us, kept making the same mistakes time and again. This group saw what nobody else did. A pandemic was coming. We weren't prepared. The Premonition is the extraordinary story of a group who anticipated, traced and hunted the coronavirus; who understood the need to think differently, to learn from history, to question everything; and to do all of this fast, in order to act, to save lives, communities, society itself. It's a story about the workings of the human mind; about the failures and triumphs of human judgement and imagination. It's the story of how we got to now.
Penguin 9780141996578 -

Värstingar på Wall Street : rapport från en d...
Inbunden bok. Reverb. 1 uppl. 2011. 276 sidor.
Mycket gott skick. Skyddsomslag i mycket gott skick. H-18:2
Inrikes enhetsfrakt Sverige: 62 SEK- ISBN
- 9789185697335
- Titel
- Värstingar på Wall Street : rapport från en domedagsmaskin
- Författare
- Michael Lewis
- Förlag
- Reverb
- Utgivningsår
- 2011
- Omfång
- 276 sidor
- Bandtyp
- Inbunden
- Mått
- 145 x 215 mm Ryggbredd 23 mm
- Vikt
- 385 g
- Språk
- Svenska
- Baksidestext
- Samtidigt som Wall Street var sysselsatta med att skapa historiens största kreditbubbla anade ett antal outsiderinvesterare att den snart skulle explodera De satsade allt mot banksystemet och tjänade en förmögenhet.
Den hyllade ekonomiskribenten Michael Lewis berättar i Värstingar på Wall Street Rapport från en domedagsmaskin den skandalösa historien om hur det gick till när en blandning av skygga genier och missanpassade särlingar överlistade hela finansmarknaden.
När finanskraschen på den amerikanska aktiemarknaden först blev allmänt känd 2008 var den egentligen redan gårdagens nyheter. Det riktiga sammanbrottet, den ljudlösa kraschen, hade redan ägt rum på bisarra marknader nedsudlade med obegripliga värdepapper skapade för att profitera på amerikaner som inte kunde betala sina skulder. De personer som borde ha haft insikten att förutspå det oundvikliga blev paralyserade av blint hopp eller fruktan. De som kunde ha förhindrat det valde att tiga.
Finanskrisen är egentligen en omöjlig berättelse: tekniskt komplicerad och med huvudpersoner som inte ens själva begrep vad de höll på med, men Michael Lewis lyckas med det omöjliga han förvandlar finanskrisen till en engagerad sidvändare med utgångspunkt från de färgstarka aktörer som lyckades komma ut på andra sidan som vinnare.
Värstingar på Wall Street är en briljant, karaktärsdriven och svart humoristisk berättelse om hur vår ekonomi kördes i botten.
Reverb 1 9789185697335 -
 Inrikes enhetsfrakt Sverige: 62 SEK
Inrikes enhetsfrakt Sverige: 62 SEK- ISBN
- 9780141996578
- Titel
- The Premonition
- Författare
- Lewis, Michael
- Förlag
- Penguin
- Utgivningsår
- 2022
- Omfång
- 336 sidor
- Bandtyp
- Mått
- 128 x 198 mm Ryggbredd 18 mm
- Vikt
- 238 g
- Språk
- English
- Baksidestext
- In January 2020, as people started dying from a new virus in Wuhan, China, few really understood the magnitude of what was happening. Except, that is, a small group of scientific misfits who in their different ways had been obsessed all their lives with how viruses spread and replicated - and with why the governments and the institutions that were supposed to look after us, kept making the same mistakes time and again. This group saw what nobody else did. A pandemic was coming. We weren't prepared. The Premonition is the extraordinary story of a group who anticipated, traced and hunted the coronavirus; who understood the need to think differently, to learn from history, to question everything; and to do all of this fast, in order to act, to save lives, communities, society itself. It's a story about the workings of the human mind; about the failures and triumphs of human judgement and imagination. It's the story of how we got to now.
Penguin 9780141996578 -
 Inrikes enhetsfrakt Sverige: 62 SEK
Inrikes enhetsfrakt Sverige: 62 SEK- ISBN
- 9780393254594
- Titel
- The Undoing Project
- Författare
- Michael Lewis
- Förlag
- Wiley
- Utgivningsår
- 2016
- Omfång
- 368 sidor
- Bandtyp
- Inbunden
- Mått
- 166 x 243 mm Ryggbredd 30 mm
- Vikt
- 658 g
- Språk
- English
- Baksidestext
- Forty years ago, Israeli psychologists Daniel Kahneman and Amos Tversky wrote a series of breathtakingly original studies undoing our assumptions about the decision-making process. Their papers showed the ways in which the human mind erred, systematically, when forced to make judgments about uncertain situations. Their work created the field of behavioral economics, revolutionized Big Data studies, advanced evidence-based medicine, led to a new approach to government regulation, and made much of Michael Lewis's own work possible. Kahneman and Tversky are more responsible than anybody for the powerful trend to mistrust human intuition and defer to algorithms. The Undoing Project is about the fascinating collaboration between two men who have the dimensions of great literary figures. They became heroes in the university and on the battlefield-both had important careers in the Israeli military-and their research was deeply linked to their extraordinary life experiences. In the process they may well have changed, for good, mankind's view of its own mind.
Wiley 9780393254594 -

Operations strategy
Häftad bok. Pearson. Sixth Edition uppl. 2020. 475 sidor.
Mycket gott skick. Helt och rent. Här och där markeringar med överstrykningspenna
Inrikes enhetsfrakt Sverige: 62 SEK- ISBN
- 9781292317847
- Titel
- Operations strategy
- Författare
- Slack, Nigel
- Utgivningsår
- 2020
- Bandtyp
- (Hardback
- Språk
- English
- Baksidestext
- "Operations strategy is a major source of competitive advantage in for-profit businesses and the route to achieving social welfare in not-for-profit enterprises. No matter what sector, it can have a huge impact - not just in the short term, but also on an enduring basis"--
Pearson Sixth Edition 9781292317847 -

The big short : den sanna historien bakom årh...
Pocketbok. Modernista. 2020. 287 sidor.
Mycket gott skick. Finns i antikvariatet
Inrikes enhetsfrakt Sverige: 62 SEK- ISBN
- 9789178932566
- Titel
- The big short : den sanna historien bakom århundradets finanskris
- Författare
- Lewis, Michael
- Förlag
- Modernista
- Utgivningsår
- 2020
- Omfång
- 287 sidor
- Bandtyp
- Mått
- 110 x 178 mm Ryggbredd 20 mm
- Vikt
- 152 g
- Språk
- Svenska
- Baksidestext
- Bästsäljaren bakom den Oscarsbelönade filmen!»Ingen skriver bättre om siffror och pengar än Michael Lewis.« | JAN GRADVALL, DI »Jag läser Lewis av samma skäl som jag tittar på Tiger Woods. Jag kommer aldrig att spela på samma nivå, men det är bra att bli påmind då och då om hur genialitet ser ut.« | MALCOLM GLADWELL, NY TIMES BOOK REVIEW När finanskraschen på den amerikanska aktiemarknaden blev allmänt känd 2008 hade den egentligen redan pågått ett bra tag i det dolda. Den verkliga historien började nämligen på bisarra marknader, dit solljuset inte nådde och där tillsynsmyndigheterna inte ville befinna sig. Marknader där skygga genier och särlingar överlistade hela finansmarknaden och tjänade enorma summor på amerikaner som inte kunde betala sina skulder.
De insiktsfulla personer som förstod vad som hände, eller kanske hände, var paralyserade av hopp och rädsla; hur som helst sade de ingenting. Michael Lewis skriver en uppslukande, karaktärsdriven berättelse, sprängfylld av indignation och svart humor. Utifrån en handfull osannolika - verkligt osannolika - hjältar, skapar Lewis en berättelse som än en gång bevisar att han är en av de skarpaste och mest underhållande skildrarna av vår tid. MICHAEL LEWIS är den storsäljande författaren till The Big Short, The Blind Side, Liars Poker och Flash Boys. 2015 kom filmversionen av The Big Short - med Brad Pitt och Christian Bale i två av rollerna - som gjort stor succé på bio och vunnit en rad priser, bland annat en Oscar i kategorin Bästa manus efter förlaga. Michael Lewis bor i Berkeley i Kalifornien med hustru och tre barn.
Modernista 9789178932566 -

The lexical approach - the state of ELT and a...
Häftad bok. Teacher Training. 1993. 200 sidor.
Gott skick. Namn på titelsida.Engelsk utgåva.
Inrikes enhetsfrakt Sverige: 62 SEK- ISBN
- 9780906717998
- Titel
- The lexical approach - the state of ELT and a way forward
- Författare
- Lewis, Michael
- Utgivningsår
- 1993
- Språk
- English
Teacher Training. 9780906717998 -

The big short : den sanna historien bakom årh...
Inbunden bok. Modernista. 1 uppl. 2017. 287 sidor.
Mycket gott skick. Skyddsomslag i mycket gott skick.
Inrikes enhetsfrakt Sverige: 62 SEK- ISBN
- 9789177010982
- Titel
- The big short : den sanna historien bakom århundradets finanskris
- Författare
- Lewis, Michael
- Förlag
- Modernista
- Utgivningsår
- 2017
- Omfång
- 287 sidor
- Bandtyp
- Inbunden
- Mått
- 145 x 217 mm Ryggbredd 24 mm
- Vikt
- 440 g
- Språk
- Svenska
- Baksidestext
- Bästsäljaren bakom den Oscarsbelönade filmen!
»Ingen skriver bättre om siffror och pengar än Michael Lewis.« | JAN GRADVALL, DI
»Jag läser Lewis av samma skäl som jag tittar på Tiger Woods. Jag kommer aldrig att spela på samma nivå, men det är bra att bli påmind då och då om hur genialitet ser ut.« | MALCOLM GLADWELL, NY TIMES BOOK REVIEW
När finanskraschen på den amerikanska aktiemarknaden blev allmänt känd 2008 hade den egentligen redan pågått ett bra tag i det dolda. Den verkliga historien började nämligen på bisarra marknader, dit solljuset inte nådde och där tillsynsmyndigheterna inte ville befinna sig. Marknader där skygga genier och särlingar överlistade hela finansmarknaden och tjänade enorma summor på amerikaner som inte kunde betala sina skulder. De insiktsfulla personer som förstod vad som hände, eller kanske hände, var paralyserade av hopp och rädsla. Hur som helst sa de ingenting.
Michael Lewis skriver en uppslukande, karaktärsdriven berättelse, full av indignation och svart humor. Utifrån en handfull osannolika, verkligt osannolika hjältar, skapar Lewis en berättelse som än en gång bevisar att han är en av de skarpaste och mest underhållande skildrarna av vår tid.
MICHAEL LEWIS är den storsäljande författaren till The Big Short, The Blind Side, Liars Poker och Flash Boys. 2015 kom filmversionen av The Big Short - med Brad Pitt och Christian Bale i två av rollerna - som gjort stor succé på bio och vunnit en rad priser, bland annat en Oscar i kategorin Bästa manus efter förlaga. Michael Lewis bor i Berkeley i Kalifornien med hustru och tre barn.
Modernista 1 9789177010982 -
 Inrikes enhetsfrakt Sverige: 62 SEK
Inrikes enhetsfrakt Sverige: 62 SEK- ISBN
- 9780141983301
- Titel
- The Big Short
- Författare
- Lewis, Michael
- Förlag
- Penguin Books Ltd.
- Utgivningsår
- 2015
- Omfång
- 270 sidor
- Bandtyp
- Mått
- 110 x 178 mm Ryggbredd 16 mm
- Vikt
- 160 g
- Språk
- English
- Baksidestext
- While Wall Street was busy creating the biggest credit bubble of all time, a few renegade investors saw it was about to burst, bet against the banking system - and made a fortune. This book tells the story of the misfits, mavericks and geniuses who, against all odds, made the greatest financial killing in history.
Penguin Books Ltd. 9780141983301 -

Going infinite - the rise and fall of a new t...
Inbunden bok. 2023.
Nära nyskick. Skyddsomslag i nära nyskick.
Inrikes enhetsfrakt Sverige: 62 SEK- ISBN
- 9781324074335
- Titel
- Going infinite - the rise and fall of a new tycoon
- Författare
- Lewis, Michael
- Utgivningsår
- 2023
- Bandtyp
- (gebonden
- Språk
- English
- Baksidestext
- Opkomst en ondergang van cryptokoning Sam Bankman-Fried.
9781324074335 -

Flash Boys
Inbunden bok. Penguin. 2014. 274 sidor.
Mycket gott skick. Skyddsomslag i mycket gott skick. Oläst
Hylla 1Inrikes enhetsfrakt Sverige: 62 SEK- ISBN
- 9780241003633
- Titel
- Flash Boys
- Författare
- Michael Lewis
- Förlag
- Penguin
- Utgivningsår
- 2014
- Bandtyp
- Inbunden
- Mått
- 160 x 240 mm Ryggbredd 27 mm
- Vikt
- 520 g
- Språk
- English
Penguin 9780241003633 -

Bluffpoker : Minnen från mitt liv på tradingg...
Inbunden bok. Stockholm : Svenska Dagbladet. 1990.
Mycket gott skick. Skyddsomslag i hyggligt skick. Mycket fin bok. Ett hörn av skyddsomslagets bakre innerflik har rivits av (syns alltså ej utanpå), annars är också det i fint skick.
Inrikes enhetsfrakt Sverige: 62 SEK- ISBN
- 9789177382461
- Titel
- Bluffpoker : minnen från mitt liv på tradinggolvet
- Författare
- Lewis, Michael M. - Nilsson, Nils - Svenska dagbladet
- Förlag
- Stockholm : Svenska dagbladet
- Utgivningsår
- 1990
- Språk
- Svenska
Stockholm : Svenska Dagbladet 9789177382461 -
 Inrikes enhetsfrakt Sverige: 62 SEKBritish Library 9780340574478
Inrikes enhetsfrakt Sverige: 62 SEKBritish Library 9780340574478 -

Flash Boys : Uppror på Wall Street
Inbunden bok. Modernista. 2016. 281 sidor.
Nyskick. Skyddsomslag i nyskick. Oläst ex i absolut förlagsnytt nyskick
Inrikes enhetsfrakt Sverige: 62 SEK- ISBN
- 9789176458518
- Titel
- Flash Boys : Uppror på Wall Street
- Författare
- Lewis, Michael
- Förlag
- Modernista
- Utgivningsår
- 2016
- Omfång
- 281 sidor
- Bandtyp
- Inbunden
- Mått
- 146 x 217 mm Ryggbredd 27 mm
- Vikt
- 520 g
- Språk
- Svenska
- Baksidestext
- Av författaren till THE BIG SHORT
#1 på New York Times Bestsellerlista
»Få har bättre koll på Wall Street än författaren Michael Lewis. Ingen annan amerikan jag känner till skriver åtminstone lika underhållande om pengar och makt.« | Jan Eklund, Dagens Nyheter
»Ingen skriver bättre om siffror och pengar än Michael Lewis.« | Jan Gradvall, DI
»Skrev jag att boken var spännande? Trots att den handlar om teknik och aktieaffärer lyckas han skapa en verklighetens thriller.« | Ernst Klein, Norrköpings Tidningar
I Flash Boys skildrar ekonomijournalisten och författaren Michael Lewis hur en liten grupp upprorsmakare på Wall Street börjar inse att den amerikanska aktiemarknaden har riggats för att gynna folk på insidan. De slår sig samman några av dem lämnar jobb med astronomiska löner bakom sig för att utforska, avslöja och reformera det bedrägliga sätt som Wall Street genererar pengar på genom högfrekvenshandel.
Flash Boys är oumbärlig läsning för alla som är intresserade av börshandel och Wall Street. Samtidigt är det en så spännande historia, så skickligt berättad, att vem som helst kommer att få svårt att lägga boken ifrån sig.
MICHAEL LEWIS är den storsäljande författaren till The Big Short, Liar s Poker, Moneyball och The Blind Side. Han bor i Berkeley i Kalifornien.
»Det här är facklitteratur, men till sin uppbyggnad liknar boken en spänningsroman.« | Kari Kapla, Dagens bok
»När vår tids historia ska berättas kommer det inte att finnas några mer oumbärliga dokument än Michael Lewis böcker. Flash Boys fullbordar en trilogi som kartlägger den högst mänskliga historien om de senaste 30 årens globala korrumption av finansmarknaderna, kanske vår epoks viktigaste men minst förstådda brott.« | The Guardian
»En mycket underhållande bok, som belyser hur mycket världen har förändrats på mindre än ett decennium.« | Los Angeles Times
»Michael Lewis är ett geni och hans bok kommer att leda till en välbehövlig granskning av högfrekvenshandeln.« | New York Magazine
»Kommer garanterat att få blodet att koka hos många.« | New York Times
»Fullkomligt uppslukande.« | New York Review of Books
»Spännande som en thriller.« | London Review of Books
Modernista 9789176458518 -

Altering Fate - Why the Past Does Not Predict...
Häftad bok. The Guilford Press, New York, 1997.
ISBN 9781572303713
Gott skick. Limhäftad, 238 sid. Noteringar och markeringar med blyerts. Språk engelska.
Inrikes enhetsfrakt Sverige: 62 SEKThe Guilford Press, New York, 1997 9781572303713 -
Your country and preferred language.
Select your country Select languageDenna webbplats använder cookies för att säkerställa att du får den bästa upplevelsen.
Stäng
Välkommen till Sveriges största bokhandel
Här finns så gott som allt som givits ut på den svenska bokmarknaden under de senaste hundra åren.
- Handla mot faktura och öppet köp i 21 dagar
- Oavsett vikt och antal artiklar handlar du till enhetsfrakt från samma säljare i samma kundvagn